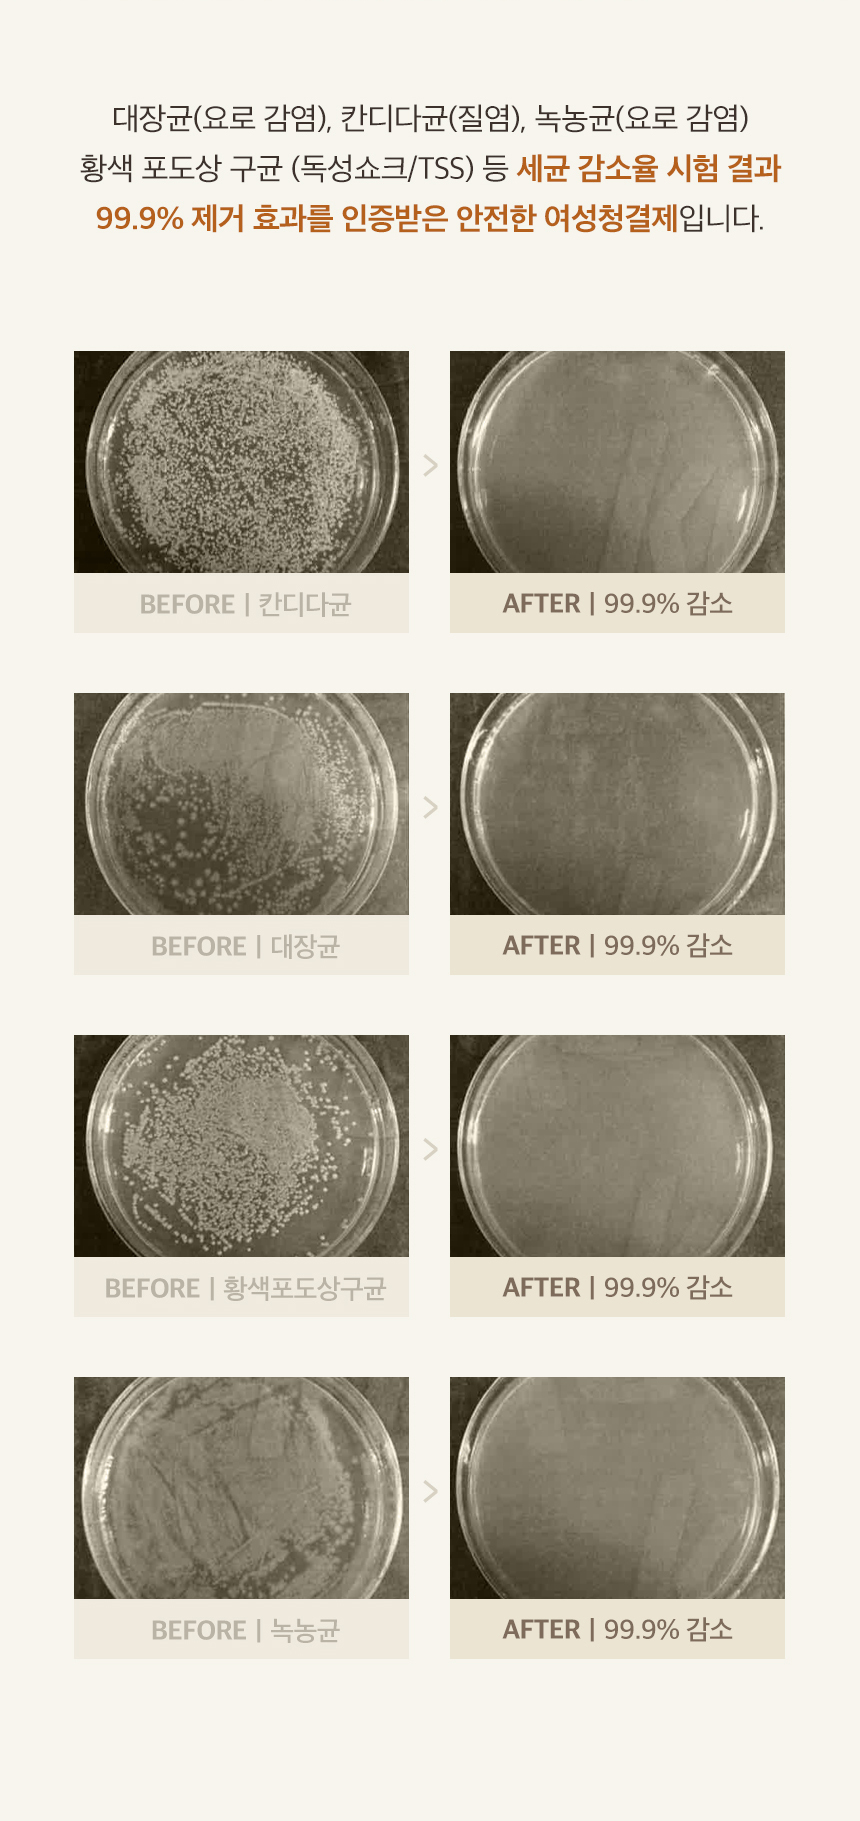

상품상세

[발주마감시간]
오전 11시

유통기한
26.05.21
[상세페이지]

상품후기 전체보기
총 평점
4.9 / 5
전체 상품후기수
116
평점 비율
- 0 1점
- 0 2점
- 1 3점
- 10 4점
- 105 5점
전체후기 116건
최신순
-
5
ckrg****
2024/06/21
-
4
dltm****
2024/05/08
-
5
pul9****
2024/04/29
-
5
vudt****
2024/04/19
-
5
wldu****
2024/02/13
상품문의 전체보기
- 4
- [기타] 전화변경문의

- 답변완료
- 박지원
- 2024/04/17
- 3
- [기타] 옵션 문의 드립니다.

- 답변완료
- 작성자
- 2024/04/16
- 2
- [배송] 배송 오류입니다.

- 답변완료
- 우필남
- 2021/10/02
- 1
- [기타] 사용빈도관련문의드려요
- 답변완료
- 민경
- 2021/09/27
- 1
배송/교환/반품
제품 안내
- 상품 준비중에는 교환/환불/취소요청이 불가합니다.
- 급하신 경우 고객센터로 연락바랍니다.
- 1:1 오더 시스템으로 재고를 가지고 있지 않아 1-3일 소요될 수 있습니다.
- 거래처 입고 지연인 경우 최대 14일 정도 기간이 소요될 수 있습니다.
- 상세사이즈 측정기준에 따라 1-3cm정도 오차가 발생할 수 있습니다.
- 위의 실측사이즈는 '단면'으로 측정됩니다.
- 제품색상은 사용자의 모니터 사양(해상도)에 따라 색상, 밝기, 명암 등이 다소 차이가 있을 수 있습니다.
- 데님 및 컬러원단 제품은 물빠짐 현상이 있을 수 있음으로 단독세탁을 권장합니다.
- 초크, 수성펜처리,실밥미처리, 잡사 등 대량생산으로 인해 발생하는
사소한 부분들은 상품의 하자가 아니므로 상품 환불이 불가합니다.
- 모든 의류의 첫 세탁은 드라이클리닝을 권장합니다.
* 잘못되 세탁방법으로 인한 상품의 불량은 당사에서 책임을 지지 않습니다.
배송 안내
- 공구 업체마다 다른 택배사를 이용하고 있습니다. 상세페이지 참조 바랍니다.
- 배송지역은 전국입니다.
- 배송비용은 제품마다 상이합니다.
- 배송준비 기간은 평균 1~4일 이내에 준비됩니다. (일,공휴일 제외)
- 재고가 없거나 재입고 될 경우 5~7일 소요됩니다.
- 조기 품절 및 제품 디테일 변경시, 개별적으로 연락을 드리고 있습니다. 이 점 양해해 주시기 바랍니다.
- 입금자명이나 입금액이 다를 경우, 고객센터로 연락주시기 바랍니다.
교환/반품
-단순 변심에 의한 반품은 상품 수령후 14일 이내에 본사에 도착해야 하고,
교환/반품시 배송비는 고객부담 입니다.
- 단 의류는 단순변심에 의한 교환/반품이 어렵습니다.
상품 하자 및 오배송 등의 사유로 교환/반품시 상품 수령후 3개월 이내에 본사에 도착해야하며, 반품 비용은 ***에서 부담 합니다.
(단, 오배송 상품의 색상 및 사이즈 변경은 2,000원 고객님 부담)
-가입 축하 무료 배송 쿠폰 이용시,
단순 변심으로 인한 제품 반품시에는
왕복 배송비를 모두 부담해주셔야 합니다.
- 제품 교환/반품 시 본품과 사은품을 모두 보내 주셔야 합니다.
- 제품이 발송된후에는 구성 변경이 불가하오니, 제품 구매시 구성을 신중하게 선택하여 구매해주세요.
- 화장품의 경우 트러블에의한 교환/반품 요청시 의사 소견서가 필요합니다.
교환/반품 불가능한 경우
- 포장을 개봉하였거나 포장이 훼손되어 상품가치가 현저히 상실된 경우
- 개봉,착용만으로 상품가치가 떨어지는 언더웨어 / 이너웨어 상품
- 아이보리 색상, 니트 경우.
- 교환/반품 불가 상품 구매시
- 상품착용,의류를 세탁, 인위적인 수선,수리를 한 경우
- 단순 변심으로 인한 반품,교환 요청이 15일을 경과한 경우
- 시간이 경과되어 재판매가 곤란한 정도로 상품가치가 상실된 경우(ex, 제품 사용기한의 경과 등)
- 상품 준비중에는 교환/환불/취소요청이 불가합니다.
- 급하신 경우 고객센터로 연락바랍니다.
- 1:1 오더 시스템으로 재고를 가지고 있지 않아 1-3일 소요될 수 있습니다.
- 거래처 입고 지연인 경우 최대 14일 정도 기간이 소요될 수 있습니다.
- 상세사이즈 측정기준에 따라 1-3cm정도 오차가 발생할 수 있습니다.
- 위의 실측사이즈는 '단면'으로 측정됩니다.
- 제품색상은 사용자의 모니터 사양(해상도)에 따라 색상, 밝기, 명암 등이 다소 차이가 있을 수 있습니다.
- 데님 및 컬러원단 제품은 물빠짐 현상이 있을 수 있음으로 단독세탁을 권장합니다.
- 초크, 수성펜처리,실밥미처리, 잡사 등 대량생산으로 인해 발생하는
사소한 부분들은 상품의 하자가 아니므로 상품 환불이 불가합니다.
- 모든 의류의 첫 세탁은 드라이클리닝을 권장합니다.
* 잘못되 세탁방법으로 인한 상품의 불량은 당사에서 책임을 지지 않습니다.
배송 안내
- 공구 업체마다 다른 택배사를 이용하고 있습니다. 상세페이지 참조 바랍니다.
- 배송지역은 전국입니다.
- 배송비용은 제품마다 상이합니다.
- 배송준비 기간은 평균 1~4일 이내에 준비됩니다. (일,공휴일 제외)
- 재고가 없거나 재입고 될 경우 5~7일 소요됩니다.
- 조기 품절 및 제품 디테일 변경시, 개별적으로 연락을 드리고 있습니다. 이 점 양해해 주시기 바랍니다.
- 입금자명이나 입금액이 다를 경우, 고객센터로 연락주시기 바랍니다.
교환/반품
-단순 변심에 의한 반품은 상품 수령후 14일 이내에 본사에 도착해야 하고,
교환/반품시 배송비는 고객부담 입니다.
- 단 의류는 단순변심에 의한 교환/반품이 어렵습니다.
상품 하자 및 오배송 등의 사유로 교환/반품시 상품 수령후 3개월 이내에 본사에 도착해야하며, 반품 비용은 ***에서 부담 합니다.
(단, 오배송 상품의 색상 및 사이즈 변경은 2,000원 고객님 부담)
-가입 축하 무료 배송 쿠폰 이용시,
단순 변심으로 인한 제품 반품시에는
왕복 배송비를 모두 부담해주셔야 합니다.
- 제품 교환/반품 시 본품과 사은품을 모두 보내 주셔야 합니다.
- 제품이 발송된후에는 구성 변경이 불가하오니, 제품 구매시 구성을 신중하게 선택하여 구매해주세요.
- 화장품의 경우 트러블에의한 교환/반품 요청시 의사 소견서가 필요합니다.
교환/반품 불가능한 경우
- 포장을 개봉하였거나 포장이 훼손되어 상품가치가 현저히 상실된 경우
- 개봉,착용만으로 상품가치가 떨어지는 언더웨어 / 이너웨어 상품
- 아이보리 색상, 니트 경우.
- 교환/반품 불가 상품 구매시
- 상품착용,의류를 세탁, 인위적인 수선,수리를 한 경우
- 단순 변심으로 인한 반품,교환 요청이 15일을 경과한 경우
- 시간이 경과되어 재판매가 곤란한 정도로 상품가치가 상실된 경우(ex, 제품 사용기한의 경과 등)
링크가 복사되었습니다.




 인스타보고 구입합니다
임산부라 바디워시로 사용...
인스타보고 구입합니다
임산부라 바디워시로 사용...
